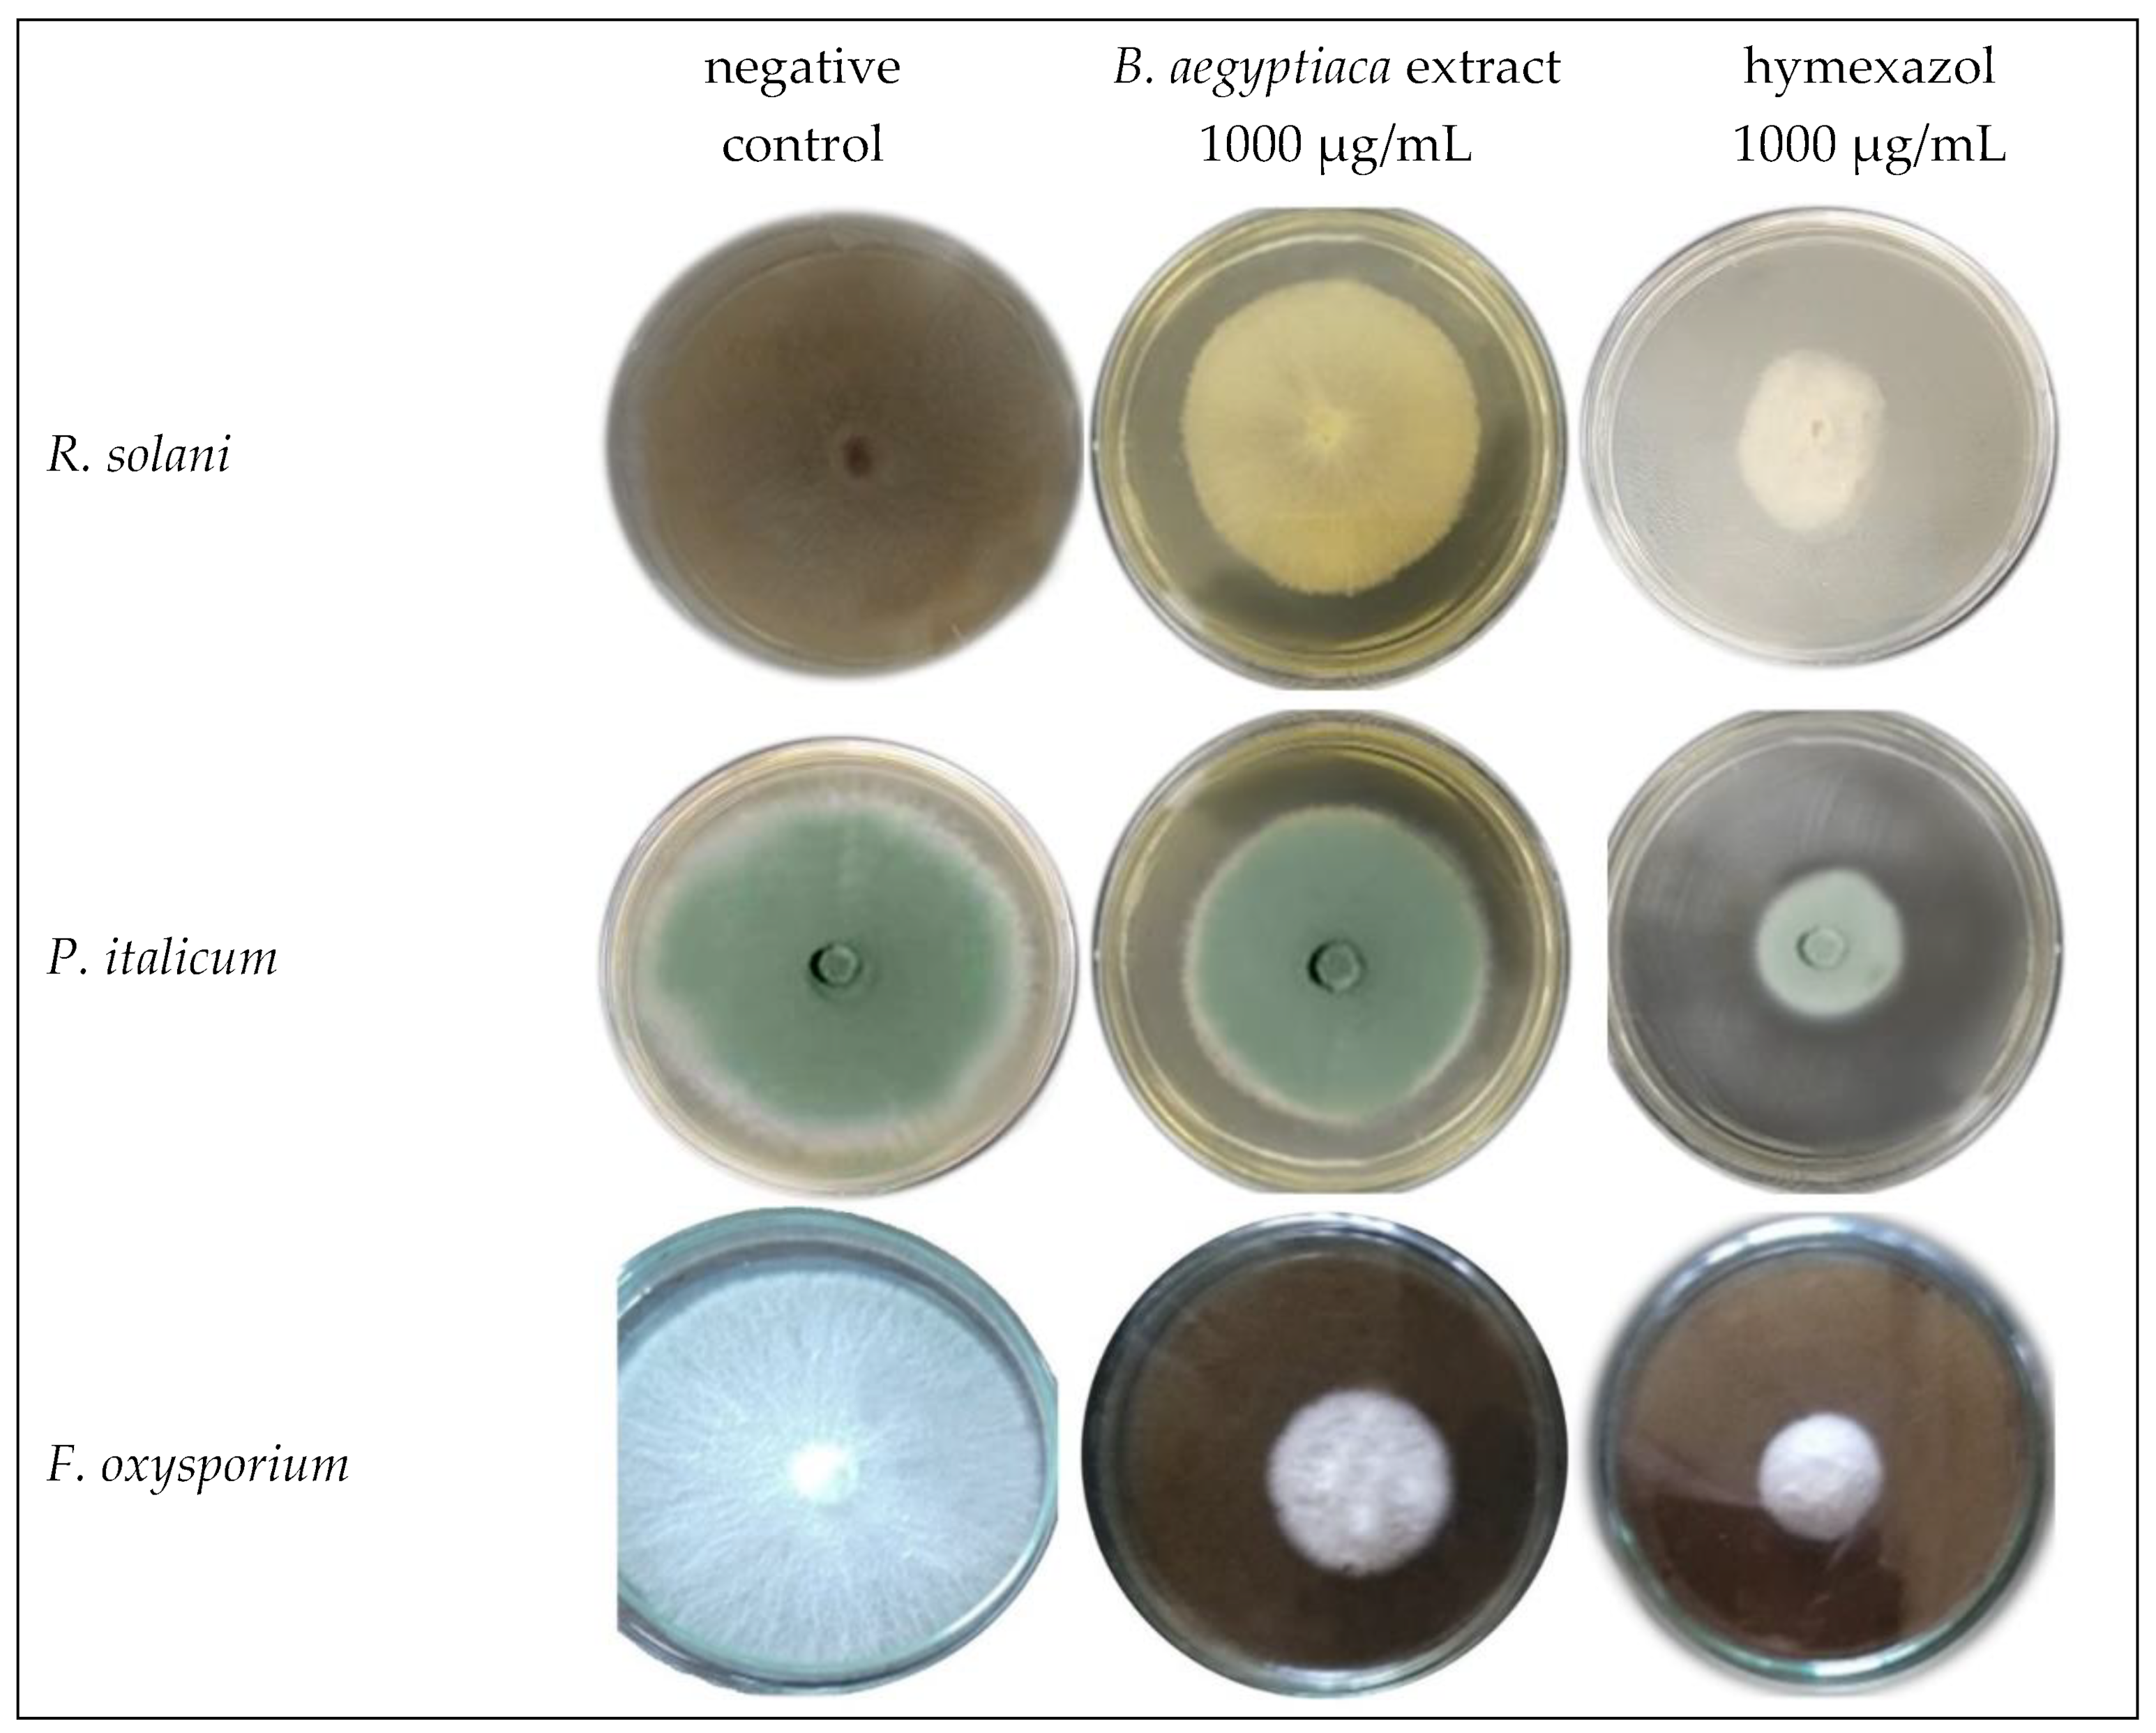

Investigation of Potential In Vitro Anticancer and Antimicrobial Activities of Balanites aegyptiaca (L.) Delile Fruit Extract and Its Phytochemical Components
Abstract
1. Introduction
2. Materials and Methods
2.1. Chemicals and Reagents
2.2. Preparation of B. aegyptiaca Fruit Extract
2.3. Gas Chromatography–Mass Spectrometry (GC–MS) Analysis
2.4. Antibacterial Activity
2.5. Antifungal Activity
2.6. Cytotoxicity Test In Vitro
2.6.1. Cell Cultures
2.6.2. MTT Assay
2.7. Cell Cycle Arrest Assessment
2.8. Assessment of Apoptotic vs. Necrotic Cells
2.9. Assessment of Apoptosis-Related Gene Expression
2.10. Statistical Analysis
3. Results
3.1. GC-MS Analysis
3.2. Antibacterial Activity
3.3. Antifungal Activity
3.4. In Vitro Cytotoxic Activity
3.5. Cell Cycle Arrest
3.6. Apoptosis and Necrosis of Cells
3.7. Expression of Apoptosis-Related Genes
4. Discussion
5. Conclusions
Author Contributions
Funding
Institutional Review Board Statement
Informed Consent Statement
Data Availability Statement
Acknowledgments
Conflicts of Interest
References
- Amadou, I. Chapter 10—Date fruits: Nutritional composition of dates (Balanites aegyptiaca Delile and Phoenix dactylifera L.). In Nutritional Composition of Fruit Cultivars; Simmonds, M.S.J., Preedy, V.R., Eds.; Academic Press: San Diego, CA, USA, 2016; pp. 215–233. [Google Scholar]
- Okia, C. Balanites aegyptiaca: A Resource for Improving Nutrition and Income of dryland Communities in Uganda. Ph.D. Thesis, Bangor University, Bangor, UK, 2010. [Google Scholar]
- Al Ashaal, H.A.; Farghaly, A.A.; Abd El Aziz, M.M.; Ali, M.A. Phytochemical investigation and medicinal evaluation of fixed oil of Balanites aegyptiaca fruits (Balantiaceae). J. Ethnopharmacol. 2010, 127, 495–501. [Google Scholar] [CrossRef] [PubMed]
- Abdelaziz, S.M.; Lemine, F.M.; Tfeil, H.O.; Filali-Maltouf, A.; Boukhary, A.O. Phytochemicals, antioxidant activity and ethnobotanical uses of Balanites aegyptiaca (L.) Del. fruits from the arid zone of Mauritania, Northwest Africa. Plants 2020, 9, 401. [Google Scholar] [CrossRef] [PubMed]
- Chapagain, B.P.; Yehoshua, Y.; Wiesman, Z. Desert date (Balanites aegyptiaca) as an arid lands sustainable bioresource for biodiesel. Bioresour. Technol. 2009, 100, 1221–1226. [Google Scholar] [CrossRef]
- Bussmann, R.W.; Paniagua-Zambrana, N.Y.; Njoroge, G.N. Balanites aegyptiaca (L.) Delile Balanites pedicellaris Mildbr. & Schltr. Balanites rotundifolia (Tiegh.) Blatt. Zygophyllaceae. In Ethnobotany of the Mountain Regions of Africa; Bussmann, R.W., Ed.; Springer International Publishing: Cham, Switzerland, 2020; pp. 1–5. [Google Scholar]
- Murthy, H.N.; Yadav, G.G.; Dewir, Y.H.; Ibrahim, A. Phytochemicals and biological activity of desert date (Balanites aegyptiaca (L.) Delile). Plants 2021, 10, 32. [Google Scholar] [CrossRef] [PubMed]
- Chothani, D.L.; Vaghasiya, H.U. A review on Balanites aegyptiaca Del (desert date): Phytochemical constituents, traditional uses, and pharmacological activity. Pharmacogn. Rev. 2011, 5, 55–62. [Google Scholar] [CrossRef] [PubMed]
- Koko, W.S.; Abdalla, H.S.; Galal, M.; Khalid, H.S. Evaluation of oral therapy on Mansonial Schistosomiasis using single dose of Balanites aegyptiaca fruits and praziquantel. Fitoterapia 2005, 76, 30–34. [Google Scholar] [CrossRef] [PubMed]
- Mohamed, A.H.; Eltahir, K.E.H.; Ali, M.B.; Galal, M.; Ayeed, I.A.; Adam, S.I.; Hamid, O.A. Some pharmacological and toxicological studies on Balanites aegyptiaca bark. Pharmacogn. Rev. 1999, 13, 439–441. [Google Scholar] [CrossRef]
- Singh, A.P.; Das, S.; Mazumder, A.; Kumar, M.; Gautam, N. A prespective review on a novel plant Balanites aegyptiaca (Linn.). J. Pharm. Biol. Sci 2017, 5, 273–277. [Google Scholar]
- Yadav, J.P.; Panghal, M. Balanites aegyptiaca (L.) Del.(Hingot): A review of its traditional uses, phytochemistry and pharmacological properties. Int. J. Green Pharm. 2010, 4, 140–146. [Google Scholar] [CrossRef]
- Mariod, A.A.; AhmedIsmail, E.M. Chapter 27—Biological activities of Balanites aegyptiaca (Heglig) kernel oil. In Multiple Biological Activities of Unconventional Seed Oils; Mariod, A.A., Ed.; Academic Press: Cambridge, MA, USA, 2022; pp. 339–344. [Google Scholar]
- Khamis, G.; Saleh, A.M.; Habeeb, T.H.; Hozzein, W.N.; Wadaan, M.A.M.; Papenbrock, J.; AbdElgawad, H. Provenance effect on bioactive phytochemicals and nutritional and health benefits of the desert date Balanites aegyptiaca. J. Food Biochem. 2020, 44, e13229. [Google Scholar] [CrossRef]
- Abdel-Farid, I.; El-Sayed, M. Phytochemical analysis of the desert date Balanites aegyptiaca. Egypt. J. Bot. 2021, 61, 95–103. [Google Scholar] [CrossRef]
- Eromosele, I.C.; Eromosele, C.O.; Akintoye, A.O.; Komolafe, T.O. Characterization of oils and chemical analyses of the seeds of wild plants. Plant Foods Hum. Nutr. 1994, 46, 361–365. [Google Scholar] [CrossRef] [PubMed]
- Mohamed, A.M.; Wolf, W.; Spieß, W.E.L. Physical, morphological and chemical characteristics, oil recovery and fatty acid composition of Balanites aegyptiaca Del. kernels. Plant Foods Hum. Nutr. 2002, 57, 179–189. [Google Scholar] [CrossRef]
- Kapseu, C.; Mbofung, C.M.F.; Kayem, G.J. Fatty acids and triglycerides of fruit oils from Cyperus esculentus and Balanites aegyptiaca. Sci. Aliment. 1997, 17, 531–537. [Google Scholar]
- Rehman, N.U.; Ansari, M.N.; Ahmad, W.; Ahamad, S.R. Dual inhibition of phosphodiesterase and Ca++ channels explains the medicinal use of Balanites aegyptiaca (L.) in hyperactive gut disorders. Plants 2022, 11, 1183. [Google Scholar] [CrossRef] [PubMed]
- Zaky, A.S.; Kandeil, M.; Abdel-Gabbar, M.; Fahmy, E.M.; Almehmadi, M.M.; Ali, T.M.; Ahmed, O.M. The Antidiabetic Effects and Modes of Action of the Balanites aegyptiaca Fruit and Seed Aqueous Extracts in NA/STZ-Induced Diabetic Rats. Pharmaceutics 2022, 14, 263. [Google Scholar] [CrossRef]
- Al-Malki, A.L.; Barbour, E.K.; Abulnaja, K.O.; Moselhy, S.S. Management of Hyperglycaemia by Ethyl Acetate Extract of Balanites aegyptiaca (Desert Date). Molecules 2015, 20, 14425–14434. [Google Scholar] [CrossRef]
- Mohamed Hussain, S.A.; Velusamy, S.; Muthusamy, J. Balanites aegyptiaca (L.) Del. for dermatophytoses: Ascertaining the efficacy and mode of action through experimental and computational approaches. Inform. Med. Unlocked 2019, 15, 100177. [Google Scholar] [CrossRef]
- Habieballa, A.G.; Alebead, H.E.; Koko, M.K.; Ibrahim, A.S.; Wady, A.F. Antimicrobial activity and physicochemical properties of Balanites aegyptiaca seed oil. Eur. J. Chem. 2021, 12, 450–453. [Google Scholar] [CrossRef]
- Khatoon, R.; Jahan, N.; Ahmad, S.; Shahzad, A. In vitro evaluation of antifungal activity of aerial parts of medicinal plants Balanites aegyptiaca Del. and Spilanthes acmella Murr. J. App. Pharm. Sci. 2014, 4, 123–127. [Google Scholar]
- Sedky, D.; Mohamed, A.M.; Fouad, R.; Khafagi, M.H.M.; Omer, E.A.; Elbayoumy, M.K.; Effat, M.M.; Abou-Zeina, H.A.A. Assessment of phytochemical, antioxidant and antibacterial activity of Balanites aegyptiaca and Curcuma longa against some bacterial pathogens isolated from dairy cow infected with mastitis. Adv. Anim. Vet. Sci 2022, 10, 160–169. [Google Scholar] [CrossRef]
- Abdallah, E.M.; Hsouna, A.B.; Al-Khalifa, K.S. Antimicrobial, antioxidant and phytochemical investigation of Balanites aegyptiaca (L.) Del. edible fruit from Sudan. Afr. J. Biotechnol. 2012, 11, 11535–11542. [Google Scholar] [CrossRef]
- Sharma, B.; Verma, N. In vitro Evaluation of Antifungal Activity of Balanites aegyptiaca Del. Ind. J. Pure App. Biosci. 2020, 8, 130–136. [Google Scholar]
- Arora, S.; Kumar, G. Phytochemical screening of root, stem and leaves of Cenchrus biflorus Roxb. J. Pharmacogn. Phytochemistry 2018, 7, 1445–1450. [Google Scholar]
- Moni, S.S.; Alam, M.F.; Sultan, M.H.; Makeen, H.A.; Alhazmi, H.A.; Mohan, S.; Alam, M.S.; Rehman, Z.U.; Jabeen, A.; Sanobar, S. Spectral analysis, in vitro cytotoxicity and antibacterial studies of bioactive principles from the leaves of Conocarpus lancifolius, a common tree of Jazan, Saudi Arabia. Braz. J. Biol. 2021, 83, 4479. [Google Scholar] [CrossRef]
- Al-Malki, A.L.; Barbour, E.K.; Abulnaja, K.O.; Moselhy, S.S.; Kumosani, T.A.; Choudhry, H. Balanites aegyptiaca protection against proliferation of different cancer cell line. Afr. J. Tradit. Complementary Altern. Med. 2016, 13, 25–30. [Google Scholar] [CrossRef][Green Version]
- Jóźwiak, M.; Filipowska, A.; Fiorino, F.; Struga, M. Anticancer activities of fatty acids and their heterocyclic derivatives. Eur. J. Pharmacol. 2020, 871, 172937. [Google Scholar] [CrossRef]
- O’Hagan, S.; Menzel, A. A subchronic 90-day oral rat toxicity study and in vitro genotoxicity studies with a conjugated linoleic acid product. Food Chem. Toxicol. 2003, 41, 1749–1760. [Google Scholar] [CrossRef]
- Bharath, B.; Perinbam, K.; Devanesan, S.; AlSalhi, M.S.; Saravanan, M. Evaluation of the anticancer potential of Hexadecanoic acid from brown algae Turbinaria ornata on HT–29 colon cancer cells. J. Mol. Struct. 2021, 1235, 130229. [Google Scholar] [CrossRef]
- Harada, H.; Yamashita, U.; Kurihara, H.; Fukushi, E.; Kawabata, J.; Kamei, Y. Antitumor activity of palmitic acid found as a selective cytotoxic substance in a marine red alga. Anticancer. Res. 2002, 22, 2587–2590. [Google Scholar]
- Jiang, L.; Wang, W.; He, Q.; Wu, Y.; Lu, Z.; Sun, J.; Liu, Z.; Shao, Y.; Wang, A. Oleic acid induces apoptosis and autophagy in the treatment of tongue squamous cell carcinomas. Sci. Rep. 2017, 7, 1–11. [Google Scholar] [CrossRef] [PubMed]
- Grattan, B.J. Plant Sterols as Anticancer Nutrients: Evidence for Their Role in Breast Cancer. Nutrients 2013, 5, 359–387. [Google Scholar] [CrossRef] [PubMed]
- Abdul-Hafeez, E.Y.; Orabi, M.A.A.; Ibrahim, O.H.M.; Ilinskaya, O.; Karamova, N.S. In vitro cytotoxic activity of certain succulent plants against human colon, breast and liver cancer cell lines. South Afr. J. Bot. 2020, 131, 295–301. [Google Scholar] [CrossRef]
- Thakur, R.S.; Ahirwar, B. A steroidal derivative from Trigonella foenum graecum L. that induces apoptosis in vitro and in vivo. J. Food Drug Anal. 2019, 27, 231–239. [Google Scholar] [CrossRef]
- Yan, C.; Xin-Ming, Q.; Li-Kun, G.; Lin-Lin, L.; Fang-Ping, C.; Ying, X.; Xiong-Fei, W.; Xiang-Hong, L.; Jin, R. Tetrandrine-induced apoptosis in rat primary hepatocytes is initiated from mitochondria: Caspases and Endonuclease G (Endo G) pathway. Toxicology 2006, 218, 1–12. [Google Scholar] [CrossRef]
- Yassin, A.M.; El-Deeb, N.M.; Metwaly, A.M.; El Fawal, G.F.; Radwan, M.M.; Hafez, E.E. Induction of Apoptosis in Human Cancer Cells Through Extrinsic and Intrinsic Pathways by Balanites aegyptiaca Furostanol Saponins and Saponin-Coated SilverNanoparticles. Appl. Biochem. Biotechnol. 2017, 182, 1675–1693. [Google Scholar] [CrossRef]
- Issa, N.M.; Mansour, F.K.; El-Safti, F.A.; Nooh, H.Z.; El-Sayed, I.H. Effect of Balanites aegyptiaca on Ehrlich Ascitic carcinoma growth and metastasis in Swiss mice. Exp. Toxicol. Pathol. 2015, 67, 435–441. [Google Scholar] [CrossRef]
- Brulez, W.; Zeller, W. Seasonal changes of epiphytic Erwinia amylovora on ornamentals in relation to weather conditions and course of infections. Acta Hortic. 1981, 117, 37–43. [Google Scholar] [CrossRef]
- Abo-Elyousr, K.A.M.; Almasoudi, N.M.; Abdelmagid, A.W.M.; Roberto, S.R.; Youssef, K. Plant extract treatments induce resistance to bacterial spot by tomato plants for a sustainable system. Horticulturae 2020, 6, 36. [Google Scholar] [CrossRef]
- Okeke, M.I.; Iroegbu, C.U.; Eze, E.N.; Okoli, A.S.; Esimone, C.O. Evaluation of extracts of the root of Landolphia owerrience for antibacterial activity. J. Ethnopharmacol. 2001, 78, 119–127. [Google Scholar] [CrossRef]
- Abdel-Hafez, S.I.I.; Abo-Elyousr, K.A.M.; Abdel-Rahim, I.R. Effectiveness of plant extracts to control purple blotch and Stemphylium blight diseases of onion (Allium cepa L.) in Assiut, Egypt. Arch. Phytopathol. Plant Prot. 2014, 47, 377–387. [Google Scholar] [CrossRef]
- Ibrahim, O.H.M.; Mousa, M.A.A.; Asiry, K.A.; Alhakamy, N.A.; Abo-Elyousr, K.A.M. Azadirachta indica A. Juss fruit mesocarp epicarp extracts induce, antimicrobial antiproliferative effects against prostate, breast colorectal adenocarcinoma cancer cell lines through upregulation of proapoptotic genes. Plants 2022, 11, 1990. [Google Scholar] [CrossRef] [PubMed]
- Ibrahim, O.H.M.; Abo-Elyousr, K.A.M.; Asiry, K.A.; Alhakamy, N.A.; Mousa, M.A.A. Phytochemical characterization, antimicrobial activity and in vitro antiproliferative potential of Alchemilla vulgaris Auct root extract against prostate (PC-3), breast (MCF-7) and colorectal adenocarcinoma (Caco-2) cancer cell lines. Plants 2022, 11, 2140. [Google Scholar] [CrossRef] [PubMed]
- Alqahtani, S.A.; Nasr, F.A.; Noman, O.M.; Farooq, M.; Alhawassi, T.; Qamar, W.; El-Gamal, A. Cytotoxic Evaluation and Anti-Angiogenic Effects of Two Furano-Sesquiterpenoids from Commiphora myrrh Resin. Molecules 2020, 25, 1318. [Google Scholar] [CrossRef] [PubMed]
- Nasr, F.A.; Noman, O.M.; Alqahtani, A.S.; Qamar, W.; Ahamad, S.R.; Al-Mishari, A.A.; Alyhya, N.; Farooq, M. Phytochemical constituents and anticancer activities of Tarchonanthus camphoratus essential oils grown in Saudi Arabia. Saudi Pharm. J. 2020, 28, 1474–1480. [Google Scholar] [CrossRef] [PubMed]
- Kuete, V. Potential of Cameroonian plants and derived products against microbial infections: A review. Planta Med. 2010, 76, 1479–1491. [Google Scholar] [CrossRef]
- Zheng, C.J.; Yoo, J.-S.; Lee, T.-G.; Cho, H.-Y.; Kim, Y.-H.; Kim, W.-G. Fatty acid synthesis is a target for antibacterial activity of unsaturated fatty acids. FEBS Lett. 2005, 579, 5157–5162. [Google Scholar] [CrossRef]
- Shaaban, M.T.; Ghaly, M.F.; Fahmi, S.M. Antibacterial activities of hexadecanoic acid methyl ester and green-synthesized silver nanoparticles against multidrug-resistant bacteria. J. Basic Microbiol. 2021, 61, 557–568. [Google Scholar] [CrossRef]
- Desbois, A.P.; Smith, V.J. Antibacterial free fatty acids: Activities, mechanisms of action and biotechnological potential. Appl. Microbiol. Biotechnol. 2010, 85, 1629–1642. [Google Scholar] [CrossRef]
- Ngamakeue, N.; Chitprasert, P. Encapsulation of Holy Basil Essential Oil in Gelatin: Effects of Palmitic Acid in Carboxymethyl Cellulose Emulsion Coating on Antioxidant and Antimicrobial Activities. Food Bioprocess Technol. 2016, 9, 1735–1745. [Google Scholar] [CrossRef]
- Yff, B.T.S.; Lindsey, K.L.; Taylor, M.B.; Erasmus, D.G.; Jäger, A.K. The pharmacological screening of Pentanisia prunelloides and the isolation of the antibacterial compound palmitic acid. J. Ethnopharmacol. 2002, 79, 101–107. [Google Scholar] [CrossRef]
- Novak, A.F.; Clark, G.C.; Dupuy, H.P. Antimicrobial activity of some ricinoleic acid oleic acid derivatives. J. Am. Oil Chem. Soc. 1961, 38, 321–324. [Google Scholar] [CrossRef]
- Semwal, P.; Painuli, S.; Badoni, H.; Bacheti, R.K. Screening of phytoconstituents and antibacterial activity of leaves and bark of Quercus leucotrichophora A. Camus from Uttarakhand Himalaya. Clin. Phytoscience 2018, 4, 30. [Google Scholar] [CrossRef]
- Khan, N.; Ali, A.; Qadir, A.; Ali, A.; Warsi, M.H.; Tahir, A.; Ali, A. GC-MS analysis and antioxidant activity of Wrightia tinctoria R.Br. leaf extract. J. AOAC Int. 2021, 104, 1415–1419. [Google Scholar] [CrossRef] [PubMed]

| No. | Compound | Retention Time (min) | Peak Area % | Chemical Formula | Molecular Weight | CAS Number |
| 1 | Octadecanoic acid, ethyl ester (Ethyl Stearate) | 4.39 | 7.58 | C20H40O2 | 312 | 111-61-5 |
| 2 | Hexadecanoic acid (Palmitic acid) | 18.37 | 21.56 | C16H32O2 | 256 | 57-10-3 |
| 3 | 9-octadecenoic acid (Z)- (Oleic acid) | 21.03 | 24.12 | C18H34O2 | 282 | 112-80-1 |
| 4 | Octadecanoic acid, 2,3-dihydroxypropyl ester (2,3-Dihydroxypropyl stearate) | 21.38 | 7.12 | C21H42O4 | 358 | 123-94-4 |
| 5 | 6,9-Octadecadiynoic acid, methyl ester (methyl 6,9-octadecadiynoate) | 23.22 | 12.78 | C19H30O2 | 290 | 56847-03-1 |
| 6 | Flavone-4’-OH,5-OH,7-di-O-glucoside | 32.29 | 3.00 | C27H30O15 | 594 | NA * |
| 7 | Stigmast-5-en-3-ol, (3 beta)- (β-sitosterol) | 34.84 | 15.57 | C29H50O | 414 | 83-46-5 |
| 8 | Ethyl iso-allocholate (Ethyl cholate) | 36.42 | 8.27 | C26H44O5 | 436 | NA |
Publisher’s Note: MDPI stays neutral with regard to jurisdictional claims in published maps and institutional affiliations. |
© 2022 by the authors. Licensee MDPI, Basel, Switzerland. This article is an open access article distributed under the terms and conditions of the Creative Commons Attribution (CC BY) license (https://creativecommons.org/licenses/by/4.0/).
Share and Cite
Ibrahim, O.H.M.; Al-Qurashi, A.D.; Asiry, K.A.; Mousa, M.A.A.; Alhakamy, N.A.; Abo-Elyousr, K.A.M. Investigation of Potential In Vitro Anticancer and Antimicrobial Activities of Balanites aegyptiaca (L.) Delile Fruit Extract and Its Phytochemical Components. Plants 2022, 11, 2621. https://doi.org/10.3390/plants11192621
Ibrahim OHM, Al-Qurashi AD, Asiry KA, Mousa MAA, Alhakamy NA, Abo-Elyousr KAM. Investigation of Potential In Vitro Anticancer and Antimicrobial Activities of Balanites aegyptiaca (L.) Delile Fruit Extract and Its Phytochemical Components. Plants. 2022; 11(19):2621. https://doi.org/10.3390/plants11192621
Chicago/Turabian StyleIbrahim, Omer H. M., Adel D. Al-Qurashi, Khalid A. Asiry, Magdi A. A. Mousa, Nabil A. Alhakamy, and Kamal A. M. Abo-Elyousr. 2022. "Investigation of Potential In Vitro Anticancer and Antimicrobial Activities of Balanites aegyptiaca (L.) Delile Fruit Extract and Its Phytochemical Components" Plants 11, no. 19: 2621. https://doi.org/10.3390/plants11192621
APA StyleIbrahim, O. H. M., Al-Qurashi, A. D., Asiry, K. A., Mousa, M. A. A., Alhakamy, N. A., & Abo-Elyousr, K. A. M. (2022). Investigation of Potential In Vitro Anticancer and Antimicrobial Activities of Balanites aegyptiaca (L.) Delile Fruit Extract and Its Phytochemical Components. Plants, 11(19), 2621. https://doi.org/10.3390/plants11192621

